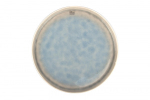
Тарелка 22cm MEDUSA

Характеристики
Бренд
Cosy&Trendy
Использование в СВЧ
Нет
Мойка в п/м
Да
Материал
керамика
ID для залива
76578
Отзывы
Отзывов еще никто не оставлял
Обращаем ваше внимание, что цены и наличие указанные на сайте, могут отличаться от фактических. Цены на продукцию, указанные в настоящем разделе, являются рекомендованными розничными ценами (РРЦ) и могут быть изменены при изменении закупочной стоимости. Также производитель оставляет за собой право менять характеристики товара без предварительного уведомления. Пожалуйста, уточняйте цену и информацию о товаре у менеджеров компании в момент оформления заказа или после оформления заказа. Информация о товаре носит справочный характер и не является публичной офертой, определяемой положениями Статьи 437 Гражданского Кодекса Российской Федерации.
Выбрать